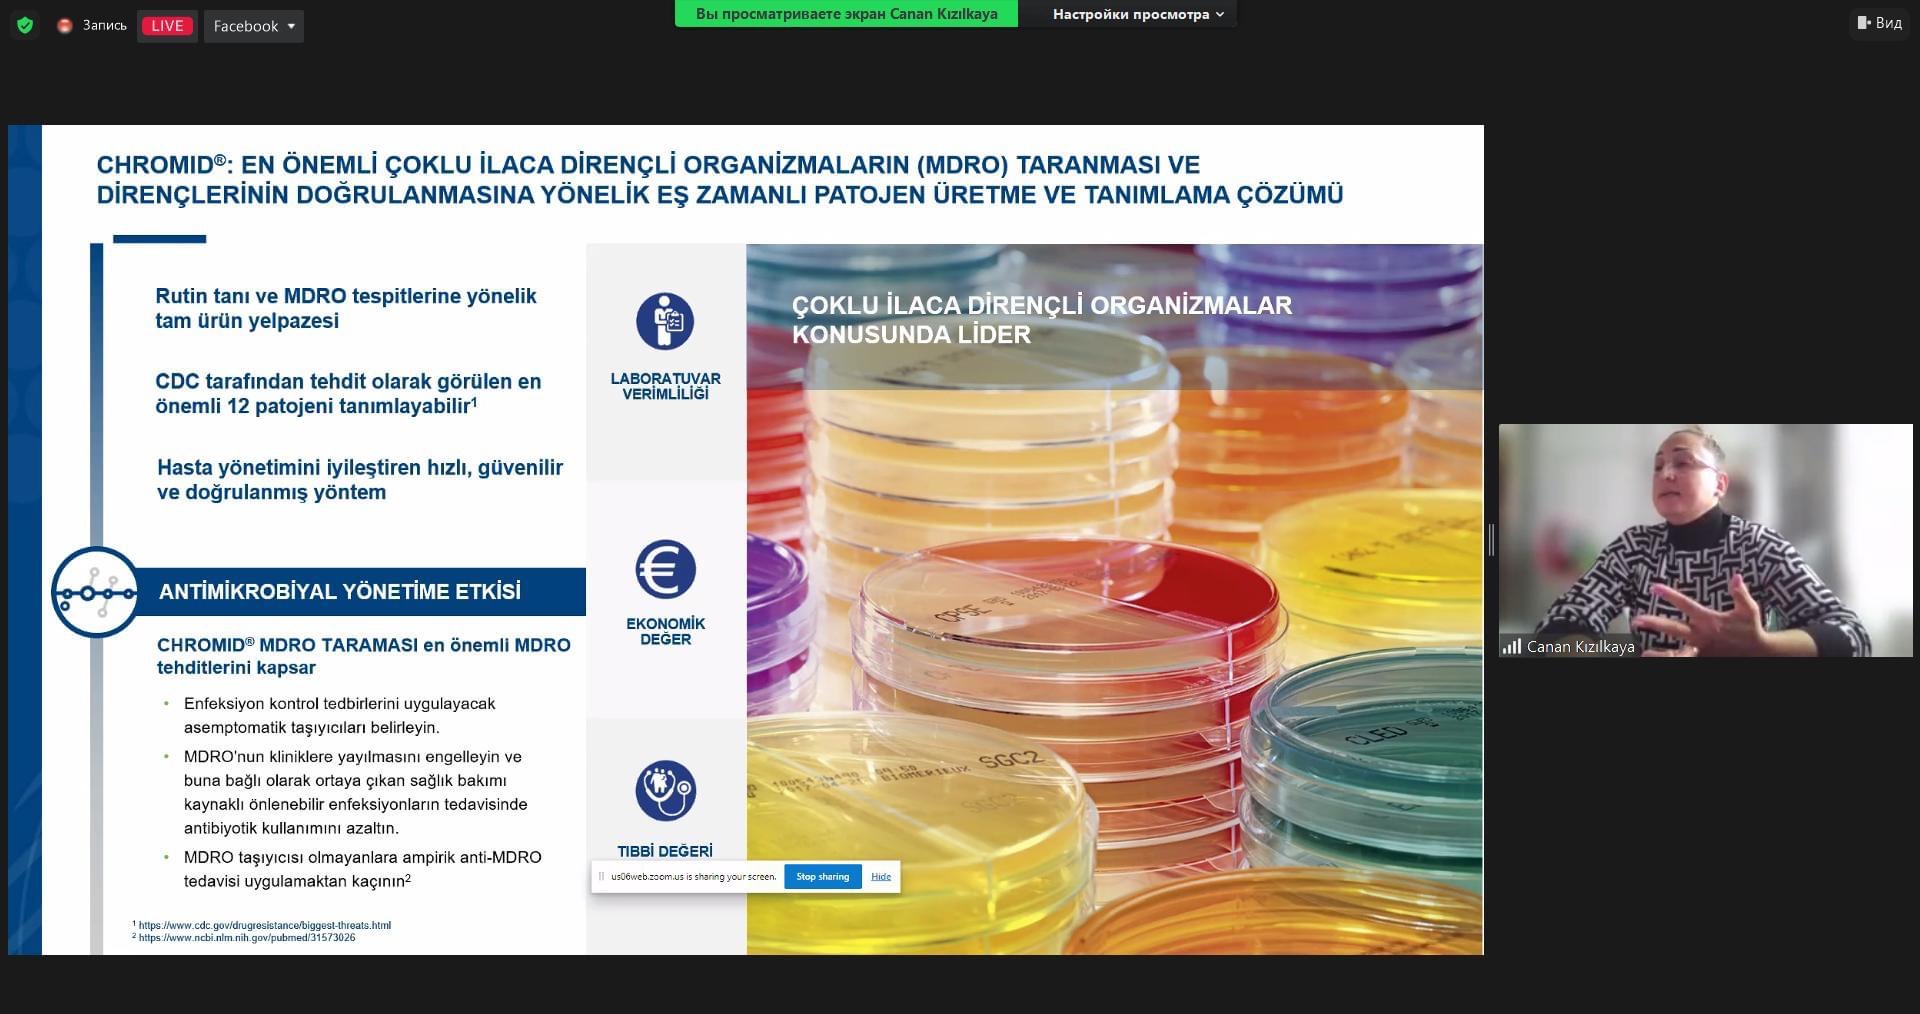

11 noyabr 2022-ci il tarixində Azərbaycan Respublikası Dövlət Gömrük Komitəsinin Tibbi Xidmət İdarəsinin Elmi-Təcrübi və Tədris Mərkəzinin, Mərkəzi Gömrük Hospitalının, Nəsil Qrup MMC və Ascent MMC şirkətlərinin birgə təşkilatçılığı ilə “Sidik yolları infeksiyalarının diaqnostikası və müalicəsinə kompleks yanaşma” mövzusunda elmi konfrans keçirilib.
Tədbirdə açılış nitqi ilə çıxış edən Mərkəzi Gömrük Hospitalının rəisi Elman Məmmədov rəhbərlik etdiyi müəssisənin ölkəmizsə yalnız müalicə və müayinə işinin təşkili ilə bağlı deyil, elmi-təcrübi mübadilənin həyata keçirilməsi aspektindən də Azərbaycan səhiyyəsində mühüm yer tutduğunu bildirib.
Mərkəzi Gömrük Hospitalının funksional və laborator diaqnostika üzrə imkanlarının bu sahədə olan ən son dünya standartlarına tam cavab verdiyini deyən E.Məmmədov Hospitalın laboratoriyasının tibbi xidmətlərin yüksək keyfiyyətinə, analiz nəticələrinin düzgünlüyünə, sənədlərə nəzarətə, risklərin minimuma endirilməsinə və hər şeydən öncə yüksək səviyyədə xəstə məmnunluğuna zəmanət verən ISO 15189:2012 sertifikatına layiq görüldüyünü vurğulayıb. O, sidik yollarının müalicə və diaqnostikası sahəsində yerli və beynəlxalq təcrübənin öyrənilməsinin nəzəri və praktiki əsaslarının vacibliyini qeyd edib.
E.Məmmədov çıxışının sonunda konfransın işinə uğurlar arzulayıb.
Konfransın rəsmi açılış hissəsində, eyni zamanda, Mərkəzi Gömrük Hospitalının Laboratoriya şöbəsinin rəisi Sevinc Gülmalıyeva da çıxış edərək sidik yollarının infeksiyalarının müalicə və diaqnostikasına kompleks yanaşmanın önəmi barədə fikirlərini bölüşüb. O, iştirakçıları sual-cavab və müzakirə sessiyalarında fəal olmağa dəvət edib.
Proqrama uyğun olaraq qabaqcıl dövlət və özəl tibb müəssisələrində çalışan laborant, virusoloq, mikrobioloq, uroloq, infeksionist, uşaq cərrahı, histomorfoloq ixtisasına malik həkimlərin, o cümlədən rezidentlərin iştirak etdiyi tədbirib elmi hissəsində sidik yolları infeksiyalarının diaqnostika və müalicəsi ilə bağlı tibbin ən son yeniliklərini özündə əks etdirən məruzələr təqdim edilib.
Hibrid formatda həyata keçirilən konfrans Azərbaycan Respublikası Səhiyyə Nazirliyinin "Davamlı Tibbi Təhsil üzrə elm və tədris tədbirlərinin akkreditasiya Qaydaları" əsasında akkreditasiya olunaraq 6 DTT balı qazanıb.